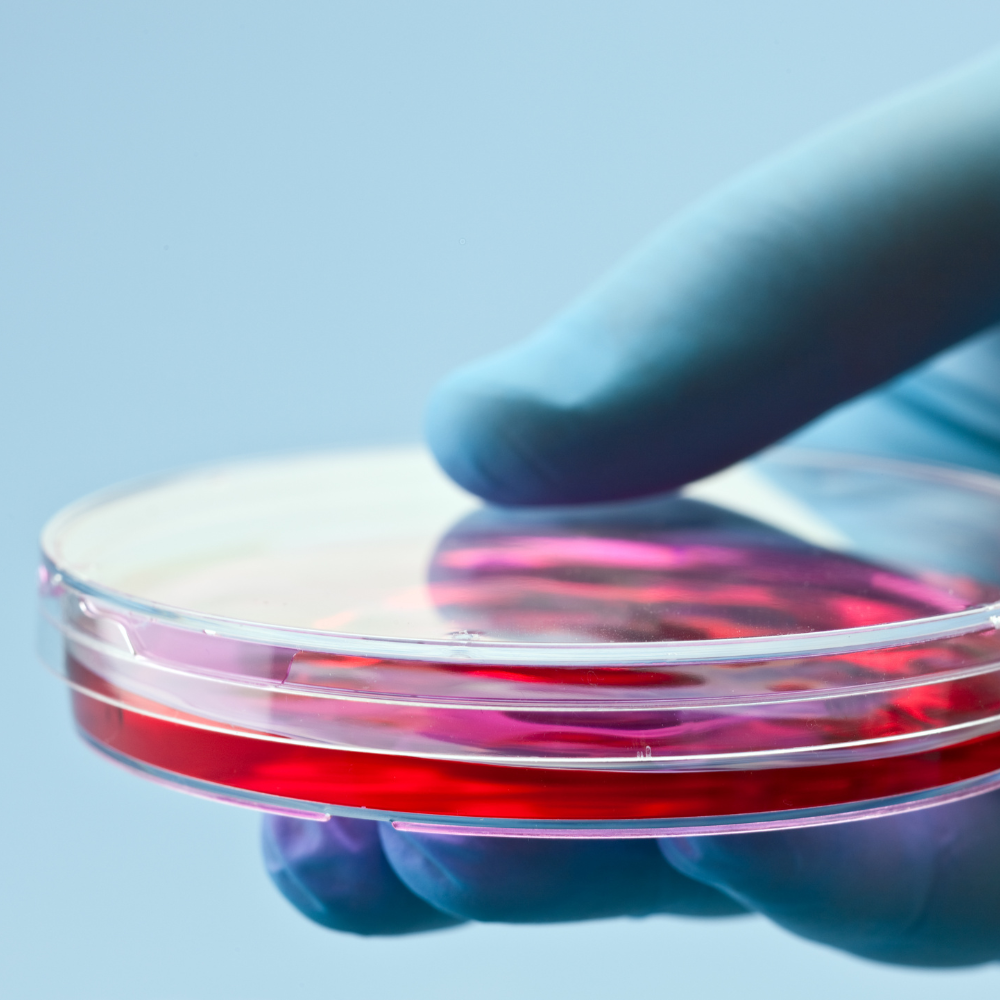
Θεραπεία Βλαστοκυττάρων

Τα Medi B in Beauty είναι ο προορισμός για όσους αναζητούν αισθητικές θεραπείες με ουσία, φροντίδα και αποτέλεσμα. Προσφέρουμε εξειδικευμένες υπηρεσίες προσώπου και σώματος με προηγμένη τεχνολογία για μια ολοκληρωμένη εμπειρία πολυτελούς περιποίησης που αναδεικνύει την πιο φωτεινή εκδοχή του εαυτού σας. Στα Medi B in Beauty παρέχουμε φροντίδα με υπογραφή υψηλής αισθητικής .
© 2025 Medi B in Beauty. All Rights Reserved | Powered by VNG Digital Group